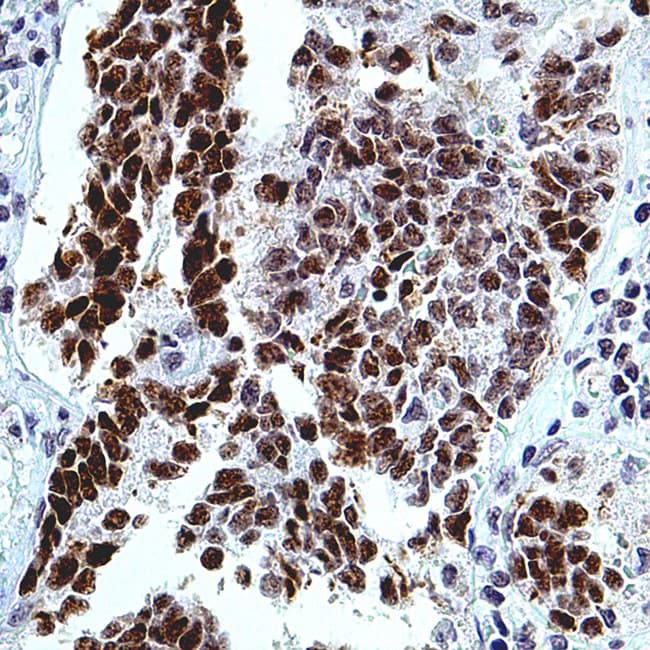

Anti-WT1 CE/IVD pour IHC - pathologies pulmonaire
La protéine WT1 (Wilm's tumor 1) est un facteur de transcription qui joue un rôle important dans le développement et la survie cellulaire. Le gène WT1 code pour un suppresseur de tumeur inactivé dans la tumeur de Wilms, récemment impliqué dans la signalisation du WNT via l'amélioration de la dégradation de la béta-caténine cytoplasmique (CTNNB1). WT1 a été trouvé dans des cellules dérivées du mésenchyme et dans la tumeur de Wilms. Les anticorps anti-WT1 sont utiles pour l'identification du mésothéliome malin. Une revue de la littérature de 88 articles publiés a suggéré que la sensibilité et la spécificité de WT1 pour l'identification du mésothéliome épithélioïde étaient respectivement de 77% et 96%. L'immunoréactivité de WT1 a également été détectée dans plusieurs types d'autres tumeurs malignes, dont le carcinome péritonéal, le carcinome du sein, le carcinome de l'ovaire et la leucémie. Dans le carcinome hépatocellulaire, l'expression de WT1 est corrélée à une réponse à la chimiothérapie. De plus, WT1 est un marqueur utile pour différencier les tumeurs desmoplastiques à petites cellules rondes (DSRCT) des autres petites tumeurs à cellules rondes.

Coupe de tumeur de Wilms
Coupe de tumeur de Wilms
Résultat de votre recherche : 9 produit(s) trouvé(s)
Affinez votre recherche :
RUOCE / IVD
- Unconjugated 9
- human 9
- Primary antibody
- mouse 9
- IHC 9
- 6F-H2 6
- IHC685 3
Référence
Description
Cond.
Prix HT
Mob437-05
0.5ml
Mob437-01
0.1ml
PDM177-25
25ml
‹
›


